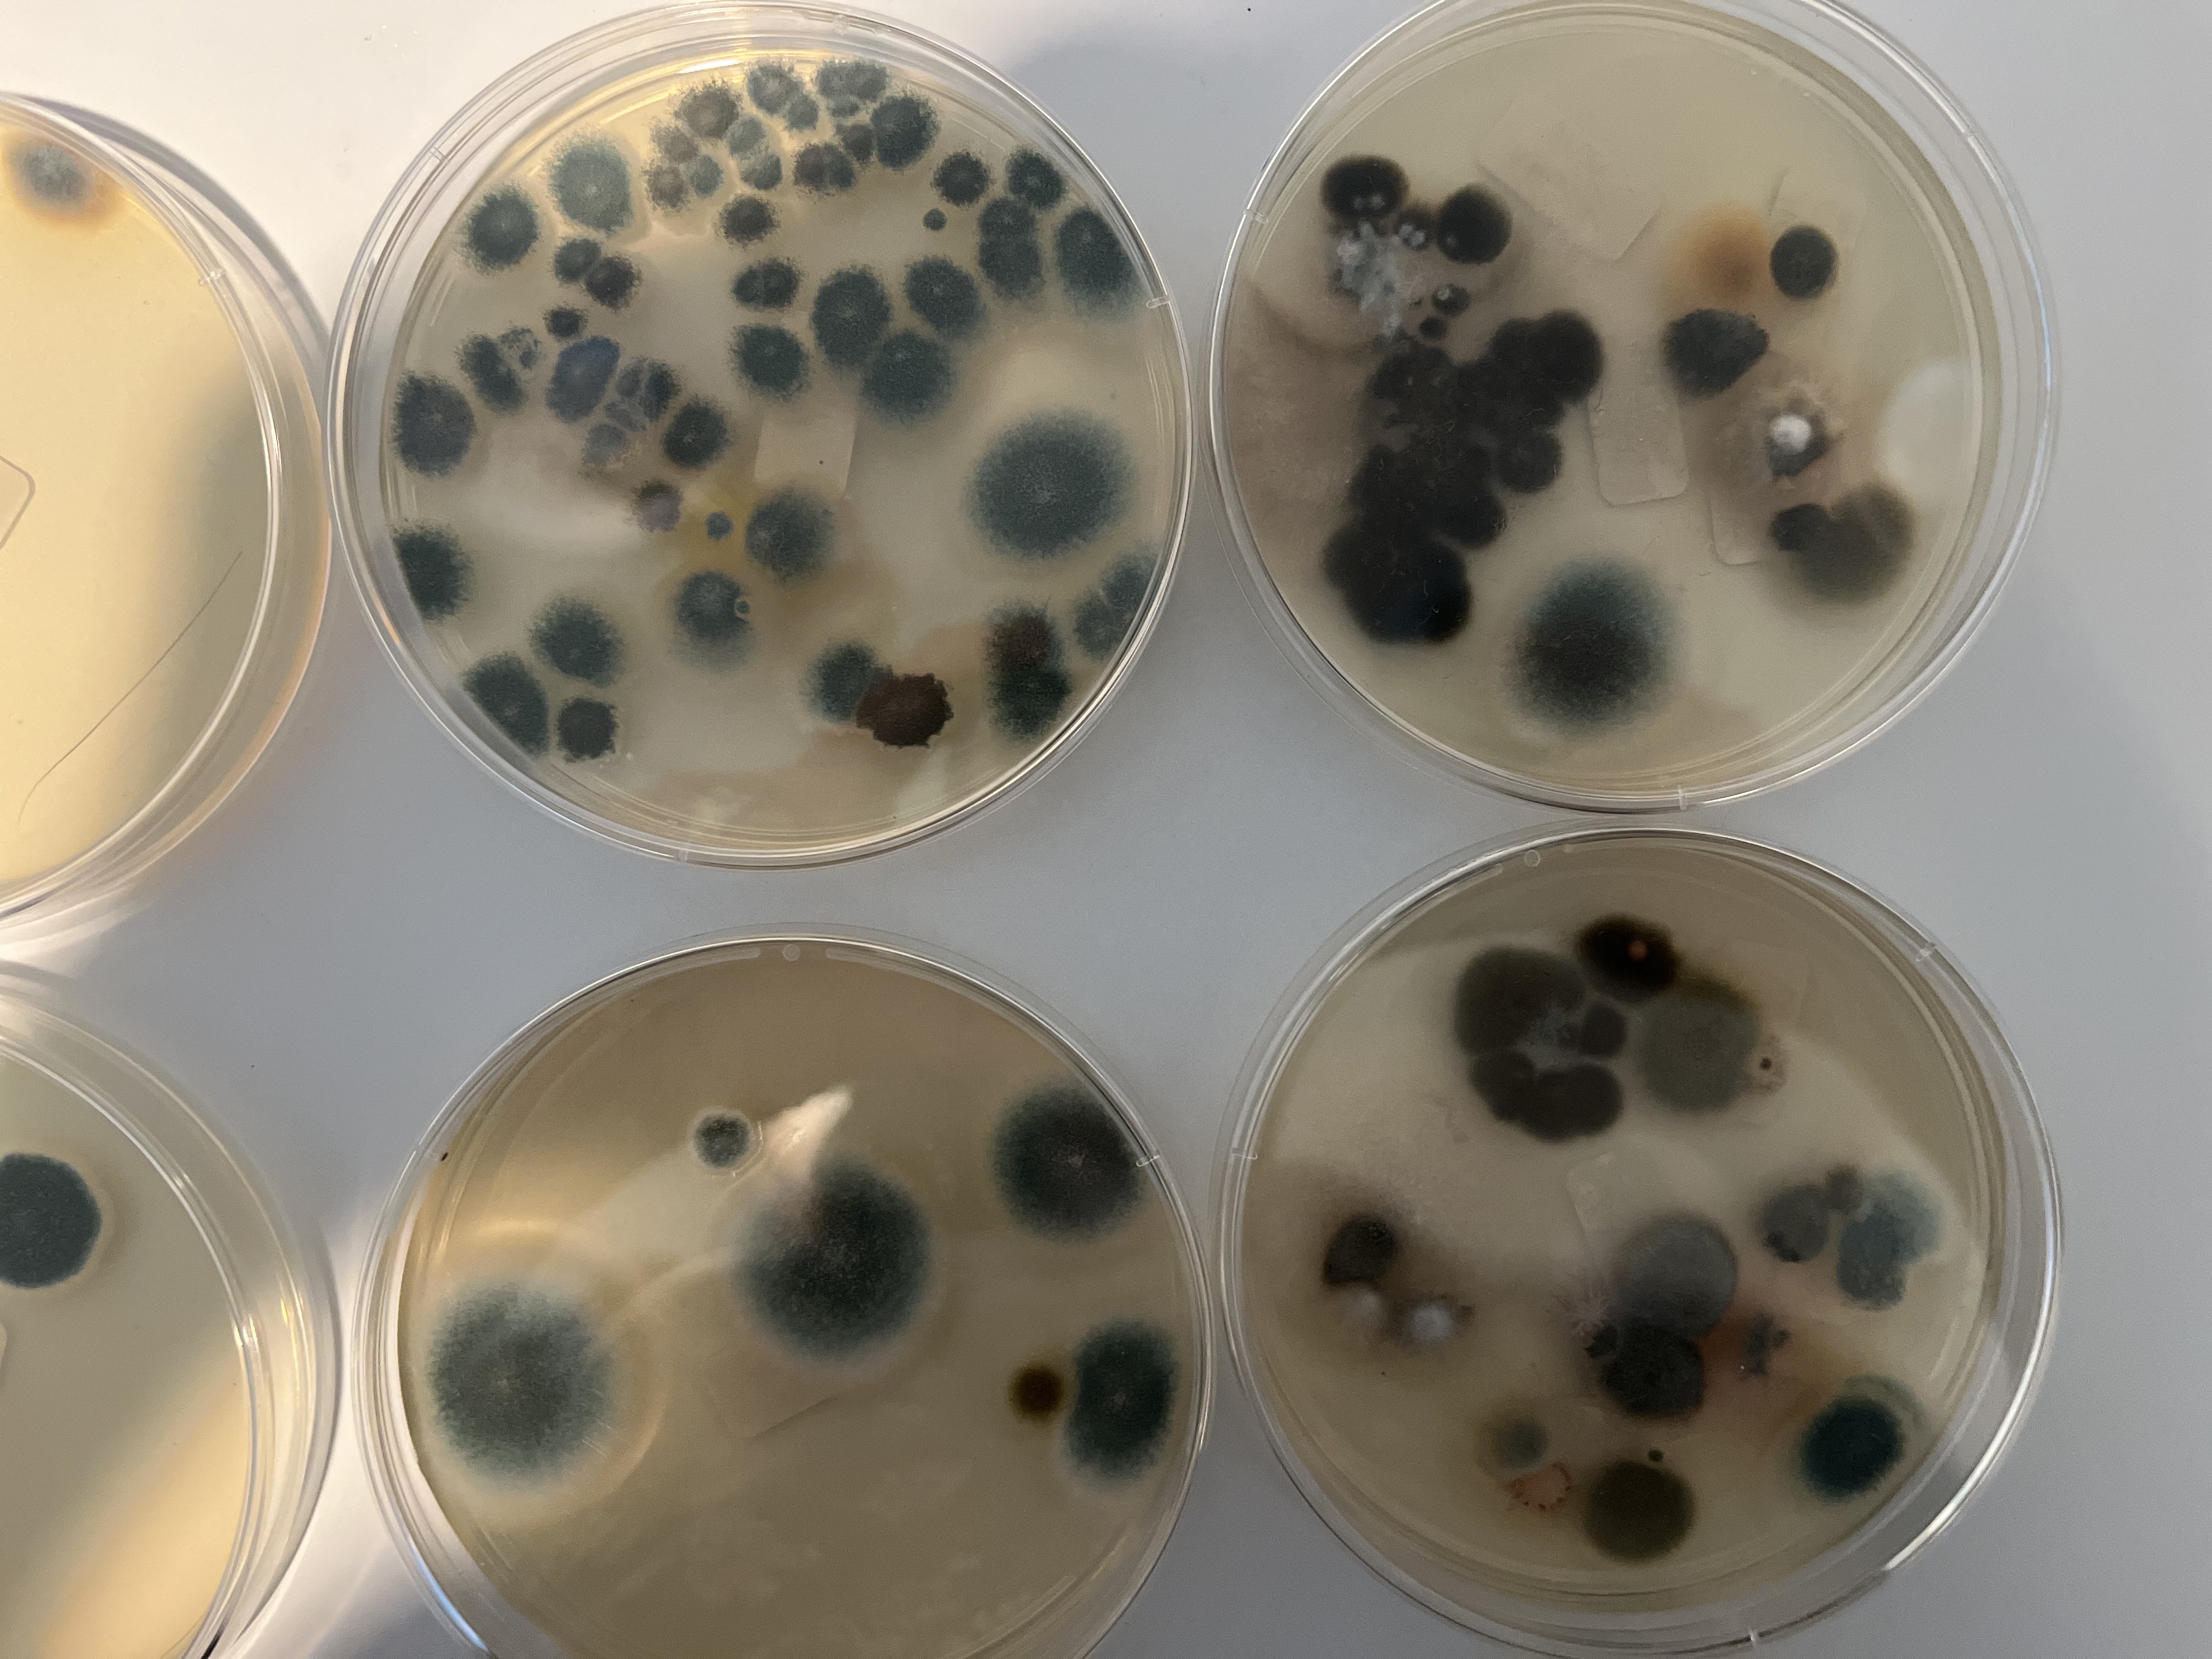

This profile has not been claimed by the business owner or representative.
to update business information, get appointment requests, engage visitors with web chat, and more!
1 Washington Blvd # 9, Ste 9, Yardville, NJ, 08691, United States
Get directions| Weekday | Schedule | Status |
|---|---|---|
| Mon | 9:00 a.m. to 6:00 p.m. | |
| Tue | 9:00 a.m. to 6:00 p.m. | |
| Wed | 9:00 a.m. to 6:00 p.m. | |
| Thu | 9:00 a.m. to 6:00 p.m. | |
| Fri | 9:00 a.m. to 6:00 p.m. | |
| Sat | Closed | |
| Sun | Closed |
I have lived in their building for 14 years and right from start I experienced everything was built cheap, elevator breaks down frequently, slow to repair, built right next to cell towers so do your Research. There are men on roof frequently when it rains vestibule had a long time leak especially after it rains I did my own mold test in their ac and air ducts and an abundance of mold grew. Stay away not built well and all original owners moved out .
House is nice. However, after one or two years the exterior needs to be repainted. Why should a new house need to be repainted? Because it was left with a splotchy paint job. Took over a year to get warranty work completed on the deck. Sharbell personnel no longer return calls.
Sharbell Development Corporation has a 2.5 star rating with 17 reviews.
Sharbell Development Corporation is open now. It will close at 6:00 p.m.
Speak with a specialist to learn how you can grow with Birdeye. We are reachable at profiles@birdeye.com